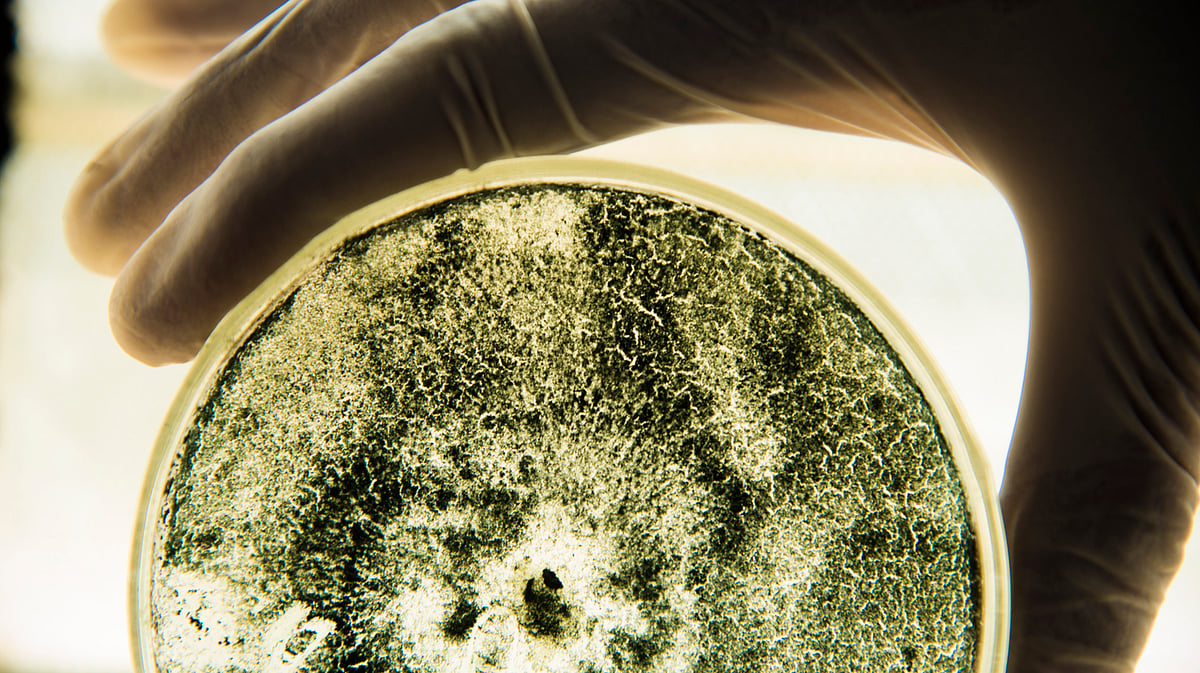

Are You Aware Of Fungal Infections And How Awful They Could Get?
Are You Aware Of Fungal Infections And How Awful They Could Get?
advertisement
For quite a long time, we had an obscurantist outlook on fungal infections.
The public notion about fungal infections is restricted to itchy rashes, ringworms, or at most to oral and vaginal thrushes. This obscurantism about fungal infections partly stems from our reductionist understanding of fungi.
We tend to be overtaken by a sense of complacency when we think of them — underestimating their pathogenic prowess and the threat posed by them to our healthcare. We have often been overlooking this part of our microbial world.
Despite the growing importance, fungal infections have met apathy from our social and political circles.
Notwithstanding the crucial roles played by the majority of fungi in nutrient recycling and keeping up the sustainability of our ecosystems; or their industrial importance as drug and food-producing work-horses, fungi are not entirely harmless and benign creatures.
This is not a hyperbole. Fungal infections are believed to have invaded cold-blooded reptiles and selected birds and mammals as the dominant landforms at the Cretaceous-tertiary boundary period of the geological time scale.
The monstrous dinosaurs couldn't resist fungal invasion, clearing the decks for warm-blooded mammals and birds. Wow! It's cool to be hot.
Fungi cause some of the ugliest and severe infections in humans — of sinuses, lungs, brain, eyes, and deadly disseminated diseases in which the infection doesn’t remain restricted to the confines of one organ but spreads to all the vital organs of our body.
Candidiasis, aspergillosis, mucormycosis, cryptococcosis, and dermatophytosis are major groups of infections caused by fungi.
The death rates associated with such diseases are not less than those due to malaria or tuberculosis.
Although bone marrow and organ transplant patients have traditionally been at risk of lethal fungal infections; in view of the changing epidemiology of fungal infections, new risk-groups like diabetes, chronic obstructive pulmonary disease, liver disease, burn patients, and post-H1N1 patients, have emerged.
Fungi snuff out as many lives as consumed by tuberculosis, as revealed by a recent estimate.
Globally, a billion people are affected by fungal infections with more than 11 million with life-threatening infections, of which 1.5 million succumb to these infections.
Candida Auris — an Emerging Global Threat
It’s noteworthy that in the recent few years, Candida auris, a new species of the Candida has created paranoia-of-sorts in the healthcare community.
C. auris continues to grab space in many leading international publications, including New York Times, Washington Post, and The Guardian, carrying alarming stories on this multidrug-resistant fungus and the precarious situation that this fungus could lead to in our infectious disease healthcare.
This uncanny fungal pathogen has put healthcare providers on tenterhooks and has started a serious discourse within the community.
The mortality rate associated with this species has been shown as high as 60%. The way this fungus has infiltrated into our healthcare in the last few years has left many baffled, scratching their heads.
This fungus is so pervasive that Mount Sinai hospital had to shovel out the floor tiles of its intensive care unit housing a C. auris candidemia patient who finally succumbed to the infection.
This fungus was first reported from the ear secretion of a 70-year-old otitis patient in Japan in 2009. Till then, its clinical significance was unknown.
However, in less than a decade, C. auris has made a saltational jump and emerged as one of the most important pathogens in the arena of hospital-acquired infections. So far, C. auris has been reported from more than 35 countries.
This pathogenic fungus is still a big enigma for the healthcare community with many of its aspects, including its evolution, its natural reservoir, and its galloping invasion across four continents yet to be thoroughly demystified.
The tropical climate of India provides a fertile ground for fungi. Also, India has a large percentage of its vast population, afflicted with type-2 diabetes.
Fungi belonging to the group, Mucorales, have a particular affinity to cause angio-invasive and life-threatening infections in patients with uncontrolled type-2 diabetes. According to one estimate, 900,000 people annually are afflicted by this group of fungi in India.
In such a scenario, can we bury our heads in the sand like an ostrich and assume everything is hunky-dory between us and the fungi?
Early diagnosis and early management of fungal infections are of utmost importance in reducing the morbidity and mortality associated with fungal infections.
The Center for Disease Control and Prevention (CDC), USA, is leading an initiative to organize fungal awareness week. This year, the week was held from 23rd -27th September with the slogan, "Think Fungus."
This slogan serves as a cue from a diagnostic perspective as some fungal infections can symptomatically masquerade as bacterial or viral infections.
So, if you don't get better with antibiotics, think the disease could be a fungal infection.
- People with uncontrolled diabetes are at risk of mucormycosis, a life threatening fungal infection.
- In North India, a spurt in the incidence of fungal rhinosinusitis (fungal infection of sinuses) in the wheat harvesting season has been noticed.
- People associated with agrarian activities are often at risk of eye injury due to vegetable/ wood splinter; predisposing themselves to fungal keratitis.
- Critical patients admitted in ICUs are prone to C.auris infection, a multi-drug resistant fungus.
- Recurrent/ relapse/ chronic ringworm patients should abstain from self-medication and consult a dermatologist for a complete cure.
(Raees ul Hamid is a Senior Research Fellow at the Department of Medical Microbiology, Postgraduate Institute of Medical Education and Research, Chandigarh)
(Author Note: The views expressed are my own and don’t necessarily represent the views of my Department or the Institute.)
(Delhi is in a public health emergency. The air outside is visibly toxic - how has the hazardous air #pollution impacted you? Write down your #PollutionKaSolution and send it to us at FIT@thequint.com.
- Access to all paywalled content on site
- Ad-free experience across The Quint
- Early previews of our Special Projects
Published: undefined